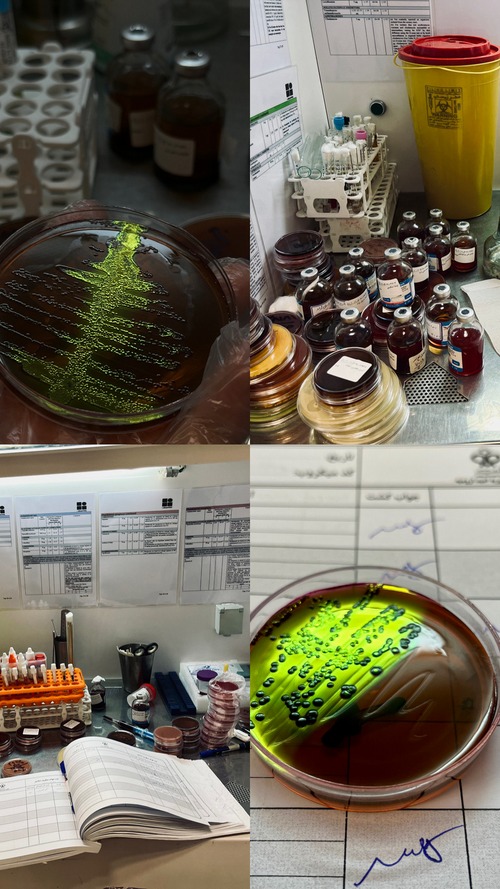

اعلام قبولی آثار هنری در اولین جشنواره هنری دانشجویی مقاومت میکروبی
با کمال مسرت به اطلاع میرسانیم که اسامی پذیرفتهشدگان نخستین جشنواره آثار هنری دانشجویی در حوزه مقاومت میکروبی و مصرف بهینه آنتیبیوتیک ها اعلام شده است. این عزیزان آثار برجستهای در قالبهای مختلف هنری همچون نقاشی، طراحی، عکاسی، اینفوگرافیک و پوستر ارائه دادهاند که به گسترش آگاهی در زمینه مقاومت میکروبی کمک شایانی خواهد کرد.
ضمن تبریک به این دانشجویان گرامی، منتظر حضور پرشور شما در مراسم جشنواره و تماشای این آثار ارزشمند هستیم
لازم به ذکر است که دو مرحله داوری برای آثار انجام شده است و در روزهای برگزاری جشنواره، مرحله نهایی داوری برای انتخاب سه نفر برتر صورت خواهد گرفت.
این جشنواره در روزهای 29 و 30 آبان ماه 1403 از ساعت 9 تا 16 در تالار شهدا (دانشکده پزشکی دانشگاه علوم پزشکی تهران) برگزار می گردد. ضروری است که پرسش نامه مرتبط با این جشنواره را تکمیل نمایید و در روزهای جشنواره نیز حضور داشته باشید.
مراسم اهدای جوایز در روز "کنفرانس علمی پیشگیری از مقاومت میکروبی و مدیریت بهینه مصرف آنتی بیوتیک ها" مورخ یک آذرماه 1403 (پنج شنبه) در تالار ابن سینا، (دانشکده پزشکی دانشگاه علوم پزشکی تهران) از ساعت 8 الی 14 برگزار خواهد شد.
از همراهی و همکاری شما سپاسگزاریم و مشتاقانه منتظر حضور شما در روز جشنواره و کنفرانس علمی هستیم.
برای اطلاعات بیشتر با شماره (021) 61192852 و یا سایت asar.tums.ac.ir تماس حاصل فرمایید.
لیست اسامی و آثار ارسالی به دبیرخانه جشنواره
زهرا نخعی- اشکان دهقان- الیسا رحمتی- پرنیا کریمی- شادی جراح کار- سوما کریمی- زهرا ناصری- زهره ابریشمی مقدم- سعید عاقبت بخیر- صادق قاسم زاده- علی معتمدی- علیرضا سعیدی- فاطمه معصومی- فرحان یونس آبادی- محمدجواد هنری- محمدرضا نادرنژاد- مریم صادقیان- میترا حدادی- مینا آگاهی- نگار ناصری- وحید محمدپور- منوچهر فدایی- یاسین رستم زاده- یسنا سالاری- ابوالفضل قمی- پرنیا طاهری- یلدا هاشمی نژاد- مریم بهرامی- شیما مرادنژاد- فاطمه پورکرمی- مهدی اصغری عظمی- سحر تشکری- مهسا ملکی- مریم زارع

.jpg)






ارسال نظر